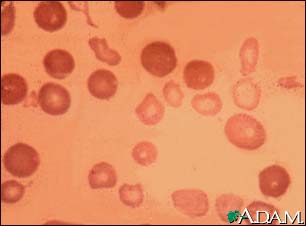
Thalassemia major Thalassemia major

|  |  |
| | ||
Thalassemia major
Thalassemia major is an inherited form of hemolytic anemia, characterized by red blood cell (hemoglobin) production abnormalities. This is the most severe form of anemia, and the oxygen depletion in the body becomes apparent within the first 6 months of life. If left untreated, death usually results within a few years. Note the small, pale (hypochromic), abnormally-shaped red blood cells associated with thalassemia major. The darker cells likely represent normal RBCs from a blood transfusion.
Update Date: 8/13/2008 Updated by: A.D.A.M. Editorial Team: David Zieve, MD, MHA, Greg Juhn, MTPW, David R. Eltz. Previously reviewed by William Matsui, MD, Assistant Professor of Oncology, Division of Hematologic Malignancies, The Sidney Kimmel Comprehensive Cancer Center at Johns Hopkins, Baltimore, MD. Review provided by VeriMed Healthcare Network (10/30/2006).
